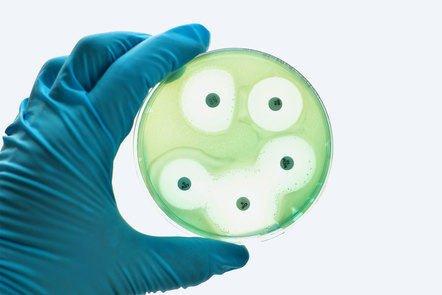

High Level Biocontainment for Healthcare Facilities (Coursera)
Discover how to provide safe, effective care for patients with highly contagious pathogens through this 4-week Coursera course. Learn essential protocols and approaches to ensure patient safety and containment within any healthcare facility.